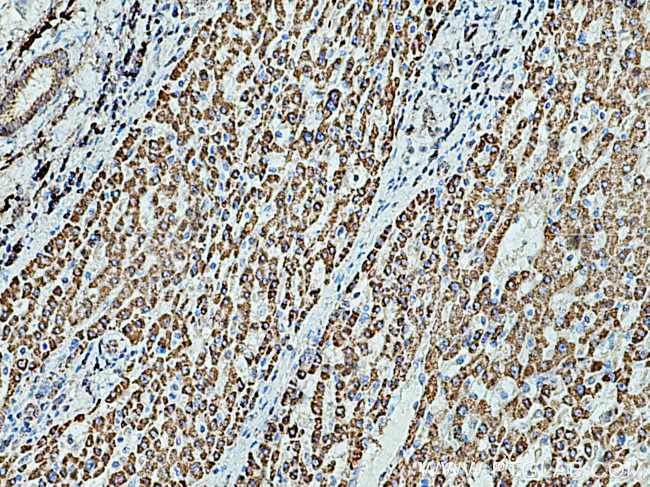
HSD17B8 Antibody in Immunohistochemistry (Paraffin) (IHC (P))

Search
Proteintech
HSD17B8 Polyclonal Antibody
{{$productOrderCtrl.translations['antibody.pdp.commerceCard.promotion.promotions']}}
{{$productOrderCtrl.translations['antibody.pdp.commerceCard.promotion.viewpromo']}}
{{$productOrderCtrl.translations['antibody.pdp.commerceCard.promotion.promocode']}}: {{promo.promoCode}} {{promo.promoTitle}} {{promo.promoDescription}}. {{$productOrderCtrl.translations['antibody.pdp.commerceCard.promotion.learnmore']}}
产品信息
16752-1-AP
种属反应
宿主/亚型
分类
类型
抗原
偶联物
形式
浓度
规格
纯化类型
保存液
内含物
保存条件
运输条件
产品详细信息
Immunogen sequence: MASQLQNRL RSALALVTGA GSGIGRAVSV RLAGEGATVA ACDLDRAAAQ ETVRLLGGPG SKEGPPRGNH AAFQADVSEA RAARCLLEQV QACFSRPPSV VVSCAGITQD EFLLHMSEDD WDKVIAVNLK GTFLVTQAAA QALVSNGCRG SIINISSIVG KVGNVGQTNY AASKAGVIGL TQTAARELGR HGIRCNSVLP GFIATPMTQK VPQKVVDKIT EMIPMGHLGD PEDVADVVAF LASEDSGYIT GTSVEVTGGL FM (1-261 aa encoded by BC008185)
靶标信息
NAD-dependent 17-beta-hydroxysteroid dehydrogenase with highest activity towards estradiol. Has very low activity towards testosterone. The heteroteramer with CBR4 has NADH-dependent 3- ketoacyl-acyl carrier protein reductase activity. May play a role in biosynthesis of fatty acids in mitochondria.
仅用于科研。不用于诊断过程。未经明确授权不得转售。
篇参考文献 (0)
生物信息学
蛋白别名: (3R)-3-hydroxyacyl-CoA dehydrogenase; 17-beta-HSD 8; 17-beta-hydroxysteroid dehydrogenase 8; 3-ketoacyl-[acyl-carrier-protein] reductase alpha subunit; 3-oxoacyl-[acyl-carrier-protein] reductase; Estradiol 17-beta-dehydrogenase 8; estrogen 17-oxidoreductase; H FABGL; KAR alpha subunit; ke-6; Ke6; Protein Ke6; really interesting new gene 2 protein; Short chain dehydrogenase/reductase family 30C member 1; Testosterone 17-beta-dehydrogenase 8
基因别名: D6S2245E; dJ1033B10.9; FABG; FABGL; H2-KE6; HKE6; HSD17B8; KE6; RING2; SDR30C1
UniProt ID: (Human) Q92506, (Rat) Q6MGB5
Entrez Gene ID: (Human) 7923, (Rat) 361802